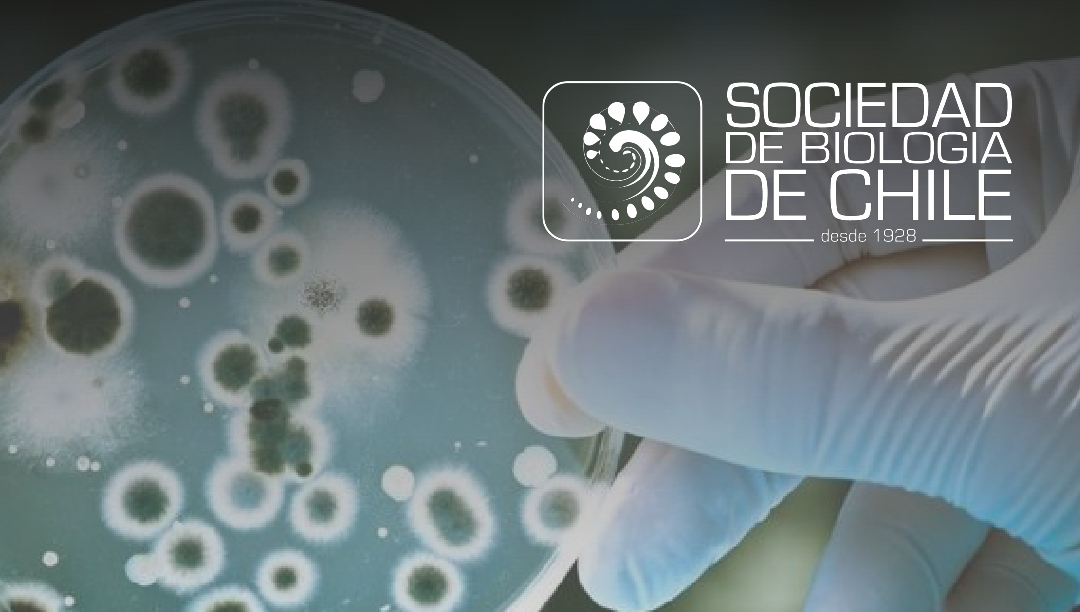

Séptima jornada del ciclo XXII Coloquios de Microbiología Valparaíso 2025
Los invitamos a la séptima jornada del ciclo XXII Coloquios de Microbiología Valparaíso 2025.
- Expositor: Prof. Eric D. van Hullebusch | Institut de Physique du Globe de Paris & Université Paris Cité, Paris, France.
- Charla: «Living Metals: Bridging Microbiology and Metallurgy in Rare Earth Element Recovery».
- Fecha y lugar: Jueves 27 de noviembre, 12:15 hrs. Auditorio B-252, Casa Central USM. Híbrido vía Zoom.
- Enlace de zoom (clave 196077)
Para tener un registro de lxs participantes, solicitamos que rellenen el siguiente formulario.

